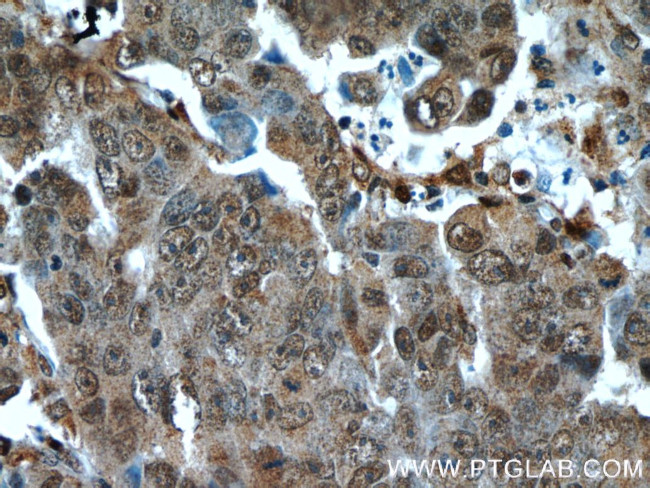
Cytoglobin Antibody in Immunohistochemistry (Paraffin) (IHC (P))
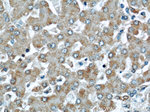
Cytoglobin Antibody in Immunohistochemistry (Paraffin) (IHC (P))

Search
Proteintech
Cytoglobin Polyclonal Antibody
{{$productOrderCtrl.translations['antibody.pdp.commerceCard.promotion.promotions']}}
{{$productOrderCtrl.translations['antibody.pdp.commerceCard.promotion.viewpromo']}}
{{$productOrderCtrl.translations['antibody.pdp.commerceCard.promotion.promocode']}}: {{promo.promoCode}} {{promo.promoTitle}} {{promo.promoDescription}}. {{$productOrderCtrl.translations['antibody.pdp.commerceCard.promotion.learnmore']}}
产品信息
13317-1-AP
种属反应
已发表种属
宿主/亚型
分类
类型
抗原
偶联物
形式
浓度
规格
纯化类型
保存液
内含物
保存条件
运输条件
产品详细信息
Immunogen sequence: MEKVPGEME IERRERSEEL SEAERKAVQA MWARLYASCE DVGVAILVRF FVNFPSAKQY FSQFKHMEDP LEMERSPQLR KHACRVMGAL NTVVENLHDP DKVSSVLALV GKAHALKHKV EPVYFKILSG VILEVVAEEF ASDFPPETQR AWAKLRGLIY SHVTAAYKEV GWVQQVPNAT TPPATLPSSG P (1-190 aa encoded by BC029798)
靶标信息
Cytoglobin is a ubiquitously expressed hexacoordinate hemoglobin that may facilitate diffusion of oxygen through tissues, scavenge nitric oxide or other reactive oxygen species, or serve a protective function during oxidative stress (Trent and Hargrove, 2002).
仅用于科研。不用于诊断过程。未经明确授权不得转售。
生物信息学
蛋白别名: Cytoglobin; HGb; Histoglobin; Nitric oxygen dioxygenase; Nitric oxygen dioxygenase CYGB; Nitrite reductase CYGB; NOD; Pseudoperoxidase CYGB; stellate cell activation associated protein; Stellate cell activation-associated protein; Superoxide dismutase CYGB; unnamed protein product
基因别名: 3110001K20Rik; CYGB; HGB; NOD; Staap; STAP
UniProt ID: (Human) Q8WWM9, (Mouse) Q9CX80, (Rat) Q921A4
Entrez Gene ID: (Human) 114757, (Mouse) 114886, (Rat) 170520